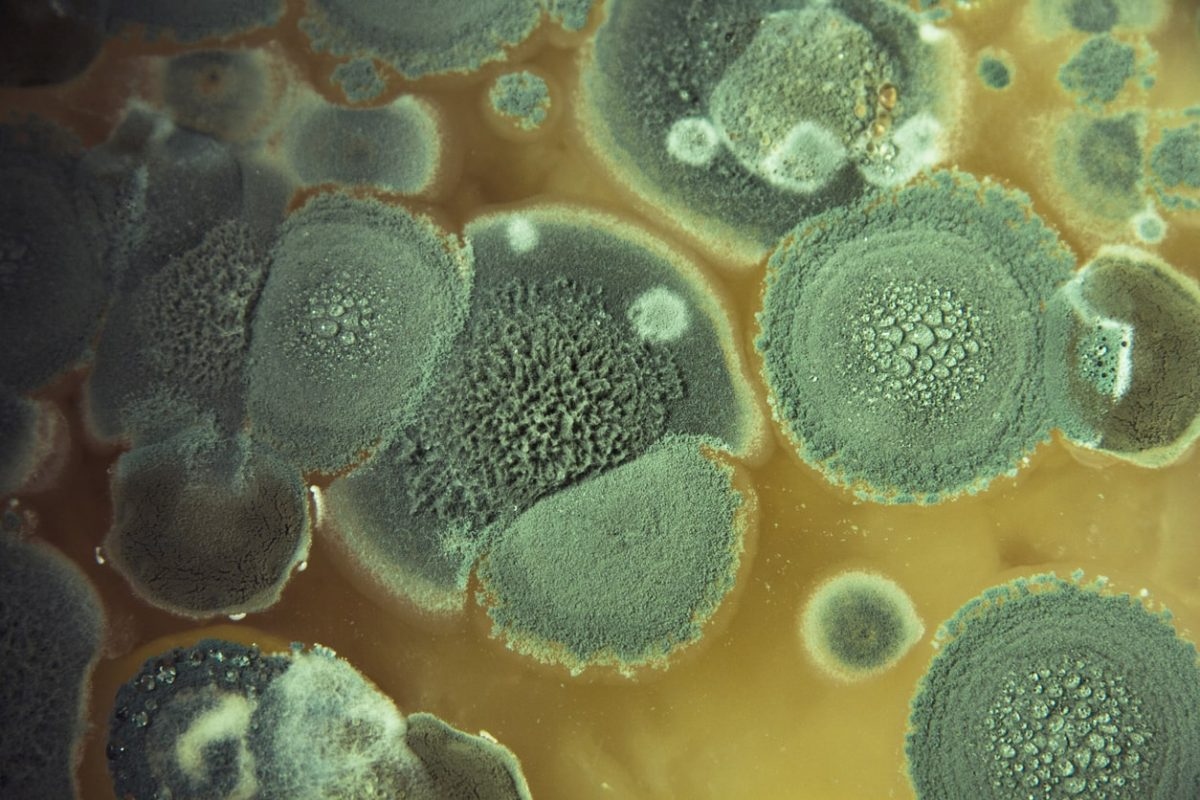

Anche se può sembrare solo un’altra combinazione casalinga, l’unione di aceto e acqua ossigenata, senza mescolarli nello stesso recipiente, può diventare uno dei detergenti più efficaci ed ecologici per la casa. Sempre più persone sostituiscono i detergenti industriali con formule naturali. Tra i trucchi che circolano maggiormente sui social network, uno spicca per la sua apparente semplicità e i suoi risultati: l’uso combinato di acqua ossigenata e aceto. Entrambi sono prodotti economici, facili da trovare e con comprovate proprietà antibatteriche. Ma c’è un dettaglio importante che gli esperti sottolineano: non devono essere mescolati nello stesso contenitore, ma applicati in successione.
A cosa serve la miscela di acqua ossigenata e aceto?
L’acqua ossigenata è un potente agente ossidante con riconosciute proprietà disinfettanti, antimicotiche e sbiancanti. Secondo l’Agenzia per la protezione dell’ambiente degli Stati Uniti (EPA), è efficace contro batteri, virus e spore di muffa, il che la rende un’alternativa sicura rispetto ad altri prodotti più aggressivi come la candeggina.
Da parte sua, l’aceto bianco agisce come antibatterico e sgrassante naturale. Uno studio pubblicato sul Journal of Environmental Health ha dimostrato che l’aceto può ridurre la presenza di alcuni batteri comuni in cucina, anche se da solo non elimina tutti i patogeni.
Separatamente, entrambi sono ottimi alleati. Ma usati uno dopo l’altro, moltiplicano la loro capacità di pulizia senza rilasciare i composti tossici dei disinfettanti convenzionali.
Perché non devono essere miscelati direttamente?
Non è sicuro mescolare entrambi i prodotti nello stesso flacone. La miscela diretta di aceto (acido acetico) e acqua ossigenata (perossido di idrogeno) produce acido peracetico, un composto corrosivo che può irritare la pelle, gli occhi e le vie respiratorie.
Per questo motivo, le autorità sanitarie, come i Centri per il controllo e la prevenzione delle malattie (CDC), raccomandano di applicarli separatamente e di lasciarli agire per alcuni secondi l’uno dopo l’altro. In questo modo si ottiene una disinfezione efficace e sicura.
Anche l’ordine è importante: prima si deve applicare l’aceto e poi l’acqua ossigenata. Questa sequenza permette di eliminare il grasso e lo sporco con l’aceto e poi di sfruttare il potere ossidante dell’acqua ossigenata per distruggere i microrganismi residui.
Usi più efficaci in casa
1. Disinfettare le superfici della cucina e del bagno.
Spruzzate l’aceto bianco su piani di lavoro, taglieri o lavandini, lasciate agire per alcuni minuti e poi applicate l’acqua ossigenata con uno spruzzino. Questa tecnica, raccomandata dalla Ohio State University, consente una disinfezione profonda senza bisogno di usare la candeggina.
2. Neutralizzare i cattivi odori.
Negli elettrodomestici come il frigorifero o il microonde, l’uso alternato di entrambi i liquidi aiuta a eliminare i batteri che causano cattivi odori e a mantenere un ambiente fresco.
3. Lavare frutta e verdura.

Applicare prima l’aceto e poi l’acqua ossigenata aiuta a ridurre i residui di pesticidi e microrganismi. Questo metodo è supportato da ricerche del Journal of Food Science che dimostrano che entrambi i composti possono ridurre la carica batterica nei prodotti freschi.
4. Sbiancare i vestiti.
Aggiungere mezza tazza di aceto al bucato e un goccio di acqua ossigenata al risciacquo finale restituisce brillantezza ai capi bianchi ed elimina gli odori senza danneggiare le fibre.
5. Disinfettare spugne e stracci.
Immergerli prima nell’aceto e poi nell’acqua ossigenata per alcuni minuti elimina fino al 99% dei batteri accumulati, secondo i dati della National Sanitation Foundation.
Precauzioni e buone pratiche
Sebbene questi ingredienti siano ecologici e sicuri, è opportuno seguire alcune regole di base:
- Non mescolarli mai nello stesso flacone o contenitore.
- Usarli sempre in luoghi ventilati.
- Effettuare una prova preliminare su zone poco visibili se si intende applicarli su superfici delicate.
- Evitare il contatto con la pelle e non usarli come sostituti dei disinfettanti medici.
Gli esperti ricordano che la pulizia della casa è fondamentale per evitare la comparsa di insetti, poiché i resti di cibo o l’umidità sono le principali attrattive per loro. Mantenere le superfici pulite e disinfettate con prodotti sicuri come l’aceto e l’acqua ossigenata riduce il rischio di infestazioni domestiche e migliora la qualità dell’aria interna.
Lungi dall’essere un semplice trucco virale, la combinazione di acqua ossigenata e aceto, utilizzata correttamente senza mescolarli, si basa su principi chimici e prove scientifiche. È un modo economico, ecologico ed efficace per mantenere pulita la casa senza ricorrere a composti tossici. Il segreto sta nel non mescolarli e lasciarli agire separatamente. In questo modo, questa coppia di detergenti naturali può trasformare la routine domestica in un’abitudine più sana e sostenibile.






